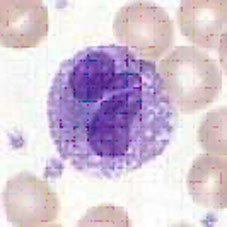
eosinófilo: célula de la sangre eosinófilo: célula de la sangre

BIOLOGÍA. LA CELULA. CARACTERISITCAS. TIPOS
Según el diccionario, la célula es la unidad anatómica fundamental de todos los seres vivos. Esta formada por citoplasma, uno o más núcleos y una membrana que la rodea. Algunos organismos, como las bacterias, constan solo de una sola célula, son organismos unicelulares. Otros, como los humanos, animales y plantas; están hechos de una cantidad incontable de células que trabajan
juntas para gestionar lo que hoy conocemos como el ser vivo. Los seres humanos estamos formados por miles de millones de células organizadas en tejidos, que forman los músculos, la piel y también órganos, como los pulmones.
vista microscópica de una célula -- eosinófilo: célula de la sangre
Según la cantidad de células, los seres vivos se clasifican en unicelulares y pluricelulares
Según la complejidad y organización de las células, se clasifican en eucariotas y procariotas. La biología estudia las células en función de su constitución molecular y la forma en que cooperan entre sí para constituir organismos muy complejos, como el ser humano. Para poder comprender cómo funciona el cuerpo humano sano, cómo se desarrolla y envejece y qué falla en caso de enfermedad, es imprescindible conocer las células que lo constituyen.
En 1665, Robert Hooke, descubrió en un corte fino de corcho, una estructura muy parecida a la de un panal de abejas. La observó con un microscopio de 50 aumentos que él mismo inventó, y llamó células a las celdillas que se formaban (del latín cellulae=celdillas). Pero Hooke observó células muertas por lo que no pudo describir su interior. En el año 1831 se descubriría finalmente el núcleo celular.
La teoría celular es la base sobre la que se sustenta gran parte de la biología. Si excluimos los virus, todos los seres vivos que forman los reinos biológicos están formados por células.
El concepto de célula como unidad funcional de los organismos surgió en los años 1830 y 1880. Las investigaciones se vieron retrasadas por el poco avance de los microscopios ópticos
La célula es la unidad esencial de todo ser vivo. Es además la estructura funcional fundamental de la materia viva según niveles de organización biológica, capaz de vivir independientemente como entidad unicelular, o bien, formar parte de una organización mayor, como un organismo pluricelular.
La célula presenta 2 modelos básicos: la procariota y eucariota. Su organización general comprende: membrana plasmática, citoplasma y ADN.
Clasificación citológica según complejidad estructural

Existen dos tipos básicos de células: procariotas y eucariotas.
(En la célula procariota, la cápsula no siempre se presenta)
Las células procariotas son estructuralmente simples. Conformaron a los primeros organismos del tipo unicelular. Éstas tienen un ADN cerrado circular, que constituye el único cromosoma, el cual se encuentra disperso en el citoplasma ausente de núcleo. La célula no tiene organelas, a excepción de ribosomas, ni estructuras especializadas. Como no poseen mitocondrias, obtienen energía del medio mediante mesosomas que son invaginaciones en la membrana. Es el tipo celular de las bacterias.
Las células eucariotas son más complejas que las procariotas. Surgieron de las células procariotas. Tiene mayor tamaño y organización más compleja con presencia de organelas, lo que permite la especialización de funciones. El ADN está contenido en un núcleo permeable rodeado de membranas. Es el tipo celular de los protozoos, hongos, plantas y animales.


